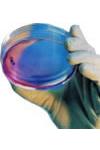
Sangue Nelle Urine

Sangue Nelle Urine
Sangue Nelle Urine
Sommario
Puo' essere il sintomo di un disturbo o la conseguenza di situazioni che non devono preoccupare. Che cosa e' bene sapere
Descrizione
La colorazione rossa delle urine viene definita dai medici ematuria. Essa puo' essere il segno di disturbi che vanno dalla semplice infiammazione delle vie urinarie fino a certi tmnori e si osserva sempre in alcune malattie del rene, della vescica e dell'uretra. Quando si scopre che nelle urine e' presente del sangue, e' necessario recarsi subito da un medico, perche' e' segno che qualcosa potrebbe non funzionare bene, soprattutto se le perdite sono frequenti e non sono accompagnate da altri disturbi.
Come si manifesta
QUANDO E' LA SPIA DI UN PROBLEMA
La presenza di una colorazione rossa nelle urine puo' dipendere da vari disturbi localizzati in uno degli organi dell'apparato urinario.
C'e' un danno ai reni
Il sangue nelle urine si puo' verificare in seguito a traumi o a incidenti che interessano la regione lombare (cioe' il fondoschiena), che possono avere danneggiato i reni.
Ci sono i calcoli
L'ematuria puo' manifestarsi in presenza di calcoli alla vescica o ai reni, perche' questi piccoli 'sassolini', muovendosi, possono provocare lesioni alle pareti degli organi coinvolti.
E' in atto un'infezione
Il sangue nelle urine puo' essere la conseguenza di una pielonefrite, cioe' un'infezione seria che interessa il rene e il bacinetto, alterandone la funzionalita'.
L'infezione si verifica, per esempio, per la presenza di calcoli che ostruiscono gli ureteri, in caso di infezione delle vie urinarie, per un reflusso di urina dall'uretra nella vescica o quando e' presente un tumore.
C'e' un tumore
Il sangue nelle urine puo' segnalare la presenza di un tumore a carico di uno degli organi dell'apparato urinario.
La prostata e' ingrossata
L'ipertrofia prostatica benigna puo' provocare, per compressione, un restringimento dell'uretra e, quindi, ematuria.
E' in corso un'infiammazione
Puo' essere a carico dell'uretere, della prostata (in questo caso a volte c'e' sangue anche nello sperma) o della vescica.
QUANDO NON DEVE PREOCCUPARE
In alcuni casi, la presenza di sangue nelle urine e' la conseguenza di situazioni che non indicano la presenza di malattie.
Dopo un rapporto sessuale
La presenza di ematuria si puo' avere anche quando la donna esegue il prelievo di urina subito dopo un rapporto sessuale. Infatti, le piccole legioni che si possono avere durante il coito possono provocare piccole emorragie di sangue.
Dopo il pap-test
Il prelievo delle cellule dal collo dell'utero per scopi diagnostici, puo' causare lacerazioni, con conseguente lieve ematuria, che potrebbe alterare il risultato dell'esame delle urine.
Durante le mestruazioni
La presenza di sangue nelle urine puo' essere dovuta al fatto di sottoporsi all'esame durante il ciclo mestruale: il sangue passa nelle urine, falsando il risultato dell'esame.
Meglio raccogliere le urine lontano dal ciclo mestruale.
Quando si pratica molto sport
Nelle persone che svolgono sport intensi, si possono verificare piccole lesioni o cambiamenti in organi come il rene, che lascia passare sangue.
Se e' solo colore
Alcuni principi attivi usati per curare certe infezioni (come la rifampicina, la nitrofurantoina, il chinino o la clorochina), oppure per guarire alcuni disturbi del sistema nervoso (come la levodopa) o per abbassare i valori della pressione del sangue (come la metildopa) possono dare una colorazione rossastra alle urine, cio' non significa che ci sia del sangue.
A volte, la causa di un arrossamento delle urine e' dovuta al consumo di cibi come le barbabietole. Appena se ne sospende il consumo, il colore delle urine torna normale.
Chi rischia di piu'
Esistono gruppi di persone piu' soggetti di altri al fenomeno dell'ematuria per malattie tumorali. Vediamo quali sono.
I forti fumatori
Le sostanze presenti nei prodotti di combustione delle sigarette, come le nitrosamine, passano nel sangue e si depositano nella vescica.
La continua deposizione di queste sostanze, puo' favorire malattie al reni o alla vescica.
I lavoratori delle industrie chimiche
Chi lavora nelle industrie chimiche che producono tipi di vernici o di solventi contenenti anilina, in quanto fanno uso di materiali potenzialmonte pericolosi.
Esami
Per scoprire la causa dell'ematuria e individuare l'organo colpito del disturbo, e' necessario sottoporsi ad alcuni esami. Vediamo i principali.
L'esame delle urine
Con questo test si puo' rilevare la presenza di eventuali malattie e disfunzioni a carico del rene.
L'urinocoltura
E' un esame utile per identificare un'eventuale presenza di infezioni alle vie urinarie.
Se l'esame segnala la presenza di germi nelle urine, sempre sulle stesse urine si esegue l'antibiogramma, che consente di scoprire a quali antibiotici i germi sono sensibili, in modo da impostare una cura mirata.
L'esame citologico
Si tratta di un esame molto utile per individuare i tumori a carico degli organi dell'apparato urinario, anche se a volte va integrato con altri accertamenti.
Dopo aver raccolto per tre giorni consecutivi le urine, il campione viene controllato al microscopio, per scoprire la presenza di cellule normali o alterate nelle urine.
La conta di Addis
Si tratta di un test che, con l'aiuto di un microscopio, conta il numero dei globuli rossi presenti nelle urine raccolte nelle ultime 24 ore.
E' utile per conoscere la serieta' del disturbo.
L'ecografia dell'addome
E' un esame indolore che, sfruttando gli ultrasuoni, verifica se sono presenti alterazioni a livello dei reni, della vescica o dell'uretra, oppure se ci sono calcoli.
L'urografia
E' un esame radiologico che si esegue iniettando in una vena del braccio una sostanza contenente iodio, un mezzo di contrasto che diventa visibile quando viene eliminato attraverso i reni.
La cistoscopia
Utilizza il microscopio, uno strumento a forma di tubo, con una fonte luminosa e alcune fibre ottiche, inrodotto nella vescica attraverso l'uretra. Consente di osservare l'interno della vescica, riscontrando la presenza di eventuali alterazioni.
L'EMATURIA E' DI DUE TIPI
Esistono due tipi di ematuria. Vediamo le differenze.
1 Microscopica
Si parla di ematuria microscopica quando il sangue non e' visibile a occhio nudo, e ci si accorge della sua presenza soltanto quando ci si sottopone all'esame delle urine per altri motivi.
Una minima parte di globuli rossi nelle urine si puo' riscontrare anche nelle persone sane.
Infatti, fino a 5 globuli rossi per campione microscopico e' un valore ritenuto normale; soltanto quando il valore supera i 5 globuli rossi per campione microscopico si e' in presenza di una vera ematuria microscopica.
E' sempre utile confermare il dato con ripetuti esami delle urine ed e' importante valutare anche la concentrazione di pus, batteri e proteine.
2 Macroscopica
Si parla di ematuria macroscopica quando il sangue e' ben visibile nelle urine a occhio nudo, e queste assumono una colorazione rossastra, a volte, anche un aspetto torbido.
La macroematuria non va mai sottovalutata e in sua presenza e' bene rivolgersi subito al medico.
Terapia
Le cure variano in base alla malattia che ha provocato il disturbo.
Se dipende da un'infezione
La cura prevede la somministrazione di antibiotici, che vengono prescritti dal medico dopo che il malato ha effettuato un esame particolare sulle urine, l'antibiogramma, per vedere quali medicine sono efficaci per sconfiggere il germe causa dell'infezione.
In caso di traumi
Il riposo a letto puo' permettere la risoluzione del problema, e bisogna bere almeno due litri di acqua al giorno, lontano dai pasti.
Invece, se il trauma e' stato serio, occorre sottoporre il malato a un intervento chirurgico, che spesso viene eseguito d'urgenza.
Quando ci sono i calcoli
In base alla sede, alla natura e alle dimensioni dei calcoli, ci sono diverse possibilita' di cura. Se si tratta di calcoli non molto grandi, l'intervento viene svolto per via endoscopica, risalendo con una piecola sonda lungo l'uretere fino a raggiungere il calcolo, che verra' frantumato ed eliminato con l'urina.
Un'altra tecnica prevede il ricorso alle onde d'urto, cioe' ultrasuoni che vengono inviati all'interno dell'organo malato, attraverso un sofisticatissimo apparecchio, allo scopo di frantumare i calcoli.
Attualmente, l'intervento di chirurgia classica e' piuttosto raro.
Se la prostata e' ingrossata
La cura medica e' a base di farmaci che riducono la congestione e l'ostruzione della ghiandola, rendendo piu' facile il passaggio dell'urina.
Se l'uso delle medicine non risolve il problema, si puo' ricorrere al trattamento chirurgico per via endoscopica: dall'uretra si fa passare un tubicino sottile, al cui interno ci sono strumenti in grado di tagliare la prostata ingrossata.
Se la prostata e' molto grossa, e' necessario l'intervento chirurgico classico, per eliminare la sua porzione ingrossata (ipertrofia prostatica benigna).
Se e' colpa di un tumore
Quando il sangue nelle urine e' dovuto a un tumore alla vescica, si hanno due possibilita'.
Se la parte malata e' circoscritta, come si verifica per esempio in caso di un papilloma vescicale, e' possibile togliere questa parte con un intervento in endoscopia. Si tratta di inserire nell'uretra una sonda, al cui interno si trovano strumenti chirurgici che permettono di asportare i papillomi. Sul tessuto asportato si esegue poi l'esame citologico, per confermare la natura della lesione (benigna o maligna).
Invece, se la parte malata e' di grosse dimensioni, e' necessaria l'asportazione chirurgica dell'organo, con conseguente deviazione delle urine, oppure, quando e' possibile, con la ricostruzione di una vescica 'artificiale' ricavata da un tratto di intestino.
Per tutte le altre forme di tumore (ai reni alla prostata o all'uretra), in genere, e' necessario l'intervento chirurgico.
Puo' essere il sintomo di un disturbo o la conseguenza di situazioni che non devono preoccupare. Che cosa e' bene sapere
Descrizione
La colorazione rossa delle urine viene definita dai medici ematuria. Essa puo' essere il segno di disturbi che vanno dalla semplice infiammazione delle vie urinarie fino a certi tmnori e si osserva sempre in alcune malattie del rene, della vescica e dell'uretra. Quando si scopre che nelle urine e' presente del sangue, e' necessario recarsi subito da un medico, perche' e' segno che qualcosa potrebbe non funzionare bene, soprattutto se le perdite sono frequenti e non sono accompagnate da altri disturbi.
Come si manifesta
QUANDO E' LA SPIA DI UN PROBLEMA
La presenza di una colorazione rossa nelle urine puo' dipendere da vari disturbi localizzati in uno degli organi dell'apparato urinario.
C'e' un danno ai reni
Il sangue nelle urine si puo' verificare in seguito a traumi o a incidenti che interessano la regione lombare (cioe' il fondoschiena), che possono avere danneggiato i reni.
Ci sono i calcoli
L'ematuria puo' manifestarsi in presenza di calcoli alla vescica o ai reni, perche' questi piccoli 'sassolini', muovendosi, possono provocare lesioni alle pareti degli organi coinvolti.
E' in atto un'infezione
Il sangue nelle urine puo' essere la conseguenza di una pielonefrite, cioe' un'infezione seria che interessa il rene e il bacinetto, alterandone la funzionalita'.
L'infezione si verifica, per esempio, per la presenza di calcoli che ostruiscono gli ureteri, in caso di infezione delle vie urinarie, per un reflusso di urina dall'uretra nella vescica o quando e' presente un tumore.
C'e' un tumore
Il sangue nelle urine puo' segnalare la presenza di un tumore a carico di uno degli organi dell'apparato urinario.
La prostata e' ingrossata
L'ipertrofia prostatica benigna puo' provocare, per compressione, un restringimento dell'uretra e, quindi, ematuria.
E' in corso un'infiammazione
Puo' essere a carico dell'uretere, della prostata (in questo caso a volte c'e' sangue anche nello sperma) o della vescica.
QUANDO NON DEVE PREOCCUPARE
In alcuni casi, la presenza di sangue nelle urine e' la conseguenza di situazioni che non indicano la presenza di malattie.
Dopo un rapporto sessuale
La presenza di ematuria si puo' avere anche quando la donna esegue il prelievo di urina subito dopo un rapporto sessuale. Infatti, le piccole legioni che si possono avere durante il coito possono provocare piccole emorragie di sangue.
Dopo il pap-test
Il prelievo delle cellule dal collo dell'utero per scopi diagnostici, puo' causare lacerazioni, con conseguente lieve ematuria, che potrebbe alterare il risultato dell'esame delle urine.
Durante le mestruazioni
La presenza di sangue nelle urine puo' essere dovuta al fatto di sottoporsi all'esame durante il ciclo mestruale: il sangue passa nelle urine, falsando il risultato dell'esame.
Meglio raccogliere le urine lontano dal ciclo mestruale.
Quando si pratica molto sport
Nelle persone che svolgono sport intensi, si possono verificare piccole lesioni o cambiamenti in organi come il rene, che lascia passare sangue.
Se e' solo colore
Alcuni principi attivi usati per curare certe infezioni (come la rifampicina, la nitrofurantoina, il chinino o la clorochina), oppure per guarire alcuni disturbi del sistema nervoso (come la levodopa) o per abbassare i valori della pressione del sangue (come la metildopa) possono dare una colorazione rossastra alle urine, cio' non significa che ci sia del sangue.
A volte, la causa di un arrossamento delle urine e' dovuta al consumo di cibi come le barbabietole. Appena se ne sospende il consumo, il colore delle urine torna normale.
Chi rischia di piu'
Esistono gruppi di persone piu' soggetti di altri al fenomeno dell'ematuria per malattie tumorali. Vediamo quali sono.
I forti fumatori
Le sostanze presenti nei prodotti di combustione delle sigarette, come le nitrosamine, passano nel sangue e si depositano nella vescica.
La continua deposizione di queste sostanze, puo' favorire malattie al reni o alla vescica.
I lavoratori delle industrie chimiche
Chi lavora nelle industrie chimiche che producono tipi di vernici o di solventi contenenti anilina, in quanto fanno uso di materiali potenzialmonte pericolosi.
Esami
Per scoprire la causa dell'ematuria e individuare l'organo colpito del disturbo, e' necessario sottoporsi ad alcuni esami. Vediamo i principali.
L'esame delle urine
Con questo test si puo' rilevare la presenza di eventuali malattie e disfunzioni a carico del rene.
L'urinocoltura
E' un esame utile per identificare un'eventuale presenza di infezioni alle vie urinarie.
Se l'esame segnala la presenza di germi nelle urine, sempre sulle stesse urine si esegue l'antibiogramma, che consente di scoprire a quali antibiotici i germi sono sensibili, in modo da impostare una cura mirata.
L'esame citologico
Si tratta di un esame molto utile per individuare i tumori a carico degli organi dell'apparato urinario, anche se a volte va integrato con altri accertamenti.
Dopo aver raccolto per tre giorni consecutivi le urine, il campione viene controllato al microscopio, per scoprire la presenza di cellule normali o alterate nelle urine.
La conta di Addis
Si tratta di un test che, con l'aiuto di un microscopio, conta il numero dei globuli rossi presenti nelle urine raccolte nelle ultime 24 ore.
E' utile per conoscere la serieta' del disturbo.
L'ecografia dell'addome
E' un esame indolore che, sfruttando gli ultrasuoni, verifica se sono presenti alterazioni a livello dei reni, della vescica o dell'uretra, oppure se ci sono calcoli.
L'urografia
E' un esame radiologico che si esegue iniettando in una vena del braccio una sostanza contenente iodio, un mezzo di contrasto che diventa visibile quando viene eliminato attraverso i reni.
La cistoscopia
Utilizza il microscopio, uno strumento a forma di tubo, con una fonte luminosa e alcune fibre ottiche, inrodotto nella vescica attraverso l'uretra. Consente di osservare l'interno della vescica, riscontrando la presenza di eventuali alterazioni.
L'EMATURIA E' DI DUE TIPI
Esistono due tipi di ematuria. Vediamo le differenze.
1 Microscopica
Si parla di ematuria microscopica quando il sangue non e' visibile a occhio nudo, e ci si accorge della sua presenza soltanto quando ci si sottopone all'esame delle urine per altri motivi.
Una minima parte di globuli rossi nelle urine si puo' riscontrare anche nelle persone sane.
Infatti, fino a 5 globuli rossi per campione microscopico e' un valore ritenuto normale; soltanto quando il valore supera i 5 globuli rossi per campione microscopico si e' in presenza di una vera ematuria microscopica.
E' sempre utile confermare il dato con ripetuti esami delle urine ed e' importante valutare anche la concentrazione di pus, batteri e proteine.
2 Macroscopica
Si parla di ematuria macroscopica quando il sangue e' ben visibile nelle urine a occhio nudo, e queste assumono una colorazione rossastra, a volte, anche un aspetto torbido.
La macroematuria non va mai sottovalutata e in sua presenza e' bene rivolgersi subito al medico.
Terapia
Le cure variano in base alla malattia che ha provocato il disturbo.
Se dipende da un'infezione
La cura prevede la somministrazione di antibiotici, che vengono prescritti dal medico dopo che il malato ha effettuato un esame particolare sulle urine, l'antibiogramma, per vedere quali medicine sono efficaci per sconfiggere il germe causa dell'infezione.
In caso di traumi
Il riposo a letto puo' permettere la risoluzione del problema, e bisogna bere almeno due litri di acqua al giorno, lontano dai pasti.
Invece, se il trauma e' stato serio, occorre sottoporre il malato a un intervento chirurgico, che spesso viene eseguito d'urgenza.
Quando ci sono i calcoli
In base alla sede, alla natura e alle dimensioni dei calcoli, ci sono diverse possibilita' di cura. Se si tratta di calcoli non molto grandi, l'intervento viene svolto per via endoscopica, risalendo con una piecola sonda lungo l'uretere fino a raggiungere il calcolo, che verra' frantumato ed eliminato con l'urina.
Un'altra tecnica prevede il ricorso alle onde d'urto, cioe' ultrasuoni che vengono inviati all'interno dell'organo malato, attraverso un sofisticatissimo apparecchio, allo scopo di frantumare i calcoli.
Attualmente, l'intervento di chirurgia classica e' piuttosto raro.
Se la prostata e' ingrossata
La cura medica e' a base di farmaci che riducono la congestione e l'ostruzione della ghiandola, rendendo piu' facile il passaggio dell'urina.
Se l'uso delle medicine non risolve il problema, si puo' ricorrere al trattamento chirurgico per via endoscopica: dall'uretra si fa passare un tubicino sottile, al cui interno ci sono strumenti in grado di tagliare la prostata ingrossata.
Se la prostata e' molto grossa, e' necessario l'intervento chirurgico classico, per eliminare la sua porzione ingrossata (ipertrofia prostatica benigna).
Se e' colpa di un tumore
Quando il sangue nelle urine e' dovuto a un tumore alla vescica, si hanno due possibilita'.
Se la parte malata e' circoscritta, come si verifica per esempio in caso di un papilloma vescicale, e' possibile togliere questa parte con un intervento in endoscopia. Si tratta di inserire nell'uretra una sonda, al cui interno si trovano strumenti chirurgici che permettono di asportare i papillomi. Sul tessuto asportato si esegue poi l'esame citologico, per confermare la natura della lesione (benigna o maligna).
Invece, se la parte malata e' di grosse dimensioni, e' necessaria l'asportazione chirurgica dell'organo, con conseguente deviazione delle urine, oppure, quando e' possibile, con la ricostruzione di una vescica 'artificiale' ricavata da un tratto di intestino.
Per tutte le altre forme di tumore (ai reni alla prostata o all'uretra), in genere, e' necessario l'intervento chirurgico.
ATTENZIONE : E' molto importante prendere atto che le informazioni contenute in queste pagine sono a carattere informativo, generico e divulgativo, pertanto devono solamente essere usate a scopo didattico e NON per diagnosi su se stessi ne sugli altri.
